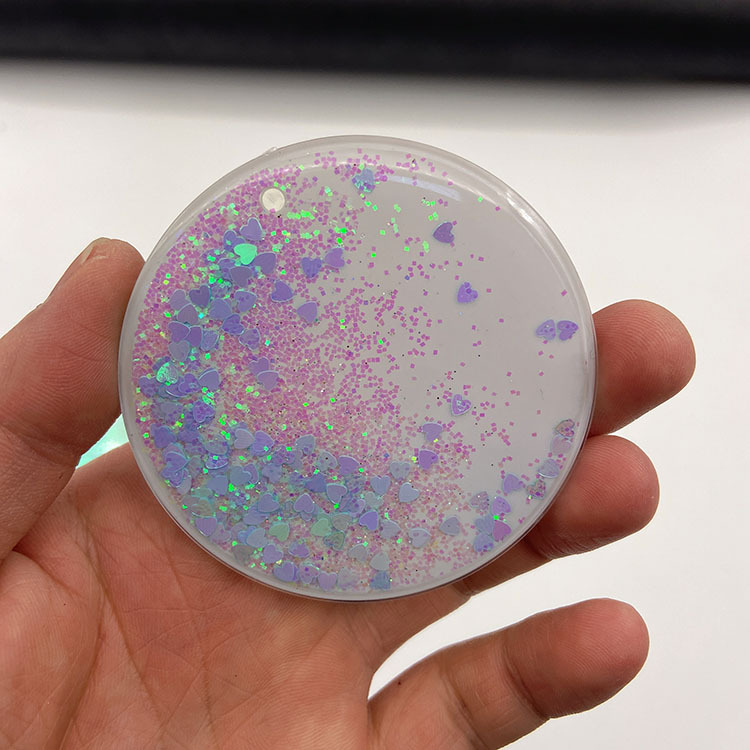
奖牌流沙片12

Акриловая медаль с песком, настраиваемый магнит для холодильника, патч 57 мм, марафонская медаль с песком, фабрика песка
Цена
¥2.00 - ¥2.50 / ≈ 24 ₽ – 30 ₽
MOQ: 500 pcs
500шт - ¥2.50 |50000шт - ¥2.30 |100000шт - ¥2.00
Продавец
东莞市妙帝电子科技有限公司
Рейтинг
0
Продано
1
Всего
В наличии
200000
SKU суммарно
Offer ID: 694182403907
Статистика продавца
4.0
Сервис
Источник: API 1688
5.0
Логистика
Источник: API 1688
5.0
Споры
Источник: API 1688
5.0
Оформление
Источник: API 1688
5.0
Консультация
Источник: API 1688
77%
Повторные покупки
Источник: API 1688
5.0
Постпродажное
Источник: API 1688
Свойства товара
Бренд Other
Код продукта 6987589
Материал Plastic
Размер 38mm
Печать логотипа Can
Чистый вес 15g
Тип Medal
использование Advanced individual medal
Можно ли настроить? Can
Поддержка смешанных заказов Is
Материалы для творчества Stainless steel plate
Основные downstream платформы Amazon, Wish, AliExpress, Independent store, Lazada, Other
Основная зона продаж Europe, South america, Southeast asia, North america, Northeast asia, Middle east, Other
Будет ли поставка товаров исключительно для трансграничного экспорта Is
Это подарок? Yes, a personal gift
Применимо к отношениям, связанным с подарками Junior, Couple, Colleague, Friend, Classmate
Применимые праздники Other
Подходит для подарков Graduation, Party gathering, Other
Описание товара
妙帝电子专注于流沙配件生产定制,可开模、注塑
产品名称:奖章奖牌流沙贴片
材质:PC
尺寸:Ø38*3.5mm/Ø57*4.1mm/ Ø68*4.2mm
定制开模周期:15-20天